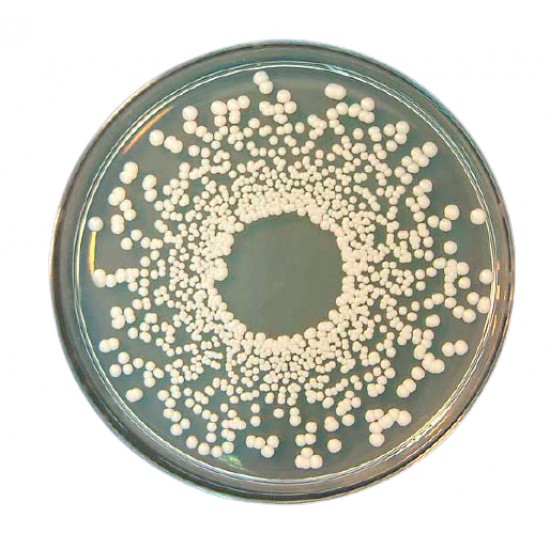
Potato Dextrose Agar (500GM)

Directions
Suspend 39 g of powder in 1 L of distilled water and bring to a boil. Distribute into suitable containers and sterilize in the autoclave at 121°C for 15 minutes. Do not overheat
Potato Dextrose Agar is a weakly selective medium for fungi due to its high sugar content and acidic pH. Pigment production and aerial mycelium development are enhanced by the potato peptone, especially in Fusarium, Aspergillus.
Penicillium species.
The selectivity can be increased by adding antibiotics such as chloramphenicol or tetracycline, or by simply decreasing the pH to an acidic level. At pH 3,5 bacterial growth is almost totally inhibited without a significant effect on fungi. This acidification can be obtained by the aseptic addition of an adequate amount of organic acid to the medium after sterilization: 10-15 mL/L of a 10% sterile solution of tartaric or lactic acid is usually sufficient. After its acidification, the medium should not be overheated or reheated since it can hydrolyze the agar causing a potential loss in the solidification property of the medium. The formulation has been adopted by the ISO 16212 standard that recommends adding chloramphenicol to the medium to increase selectivity.
Formula * in g/L
Potato peptone
4.0 (1) Glucose
20.0 Agar
15.0 Final pH 5.6 ±0.2 at 25 °C (1) Equivalent to 200 g infusion from potatoes
| Product More Specifications | |
| Specification |
Medium for the detection and enumeration of yeast and moulds in food, dairy products, and other samples, acc. to the Pharm. Harm. Formula * in g/L Potato peptone 4.0 (1) Glucose 20.0 Agar 15.0 Final pH 5.6 ±0.2 at 25 °C (1) Equivalent to 200 g infusion from potatoes |
| Made In | Spain |
- Stock: In Stock
- Model: Scharlab
- SKU: 01-483-500








